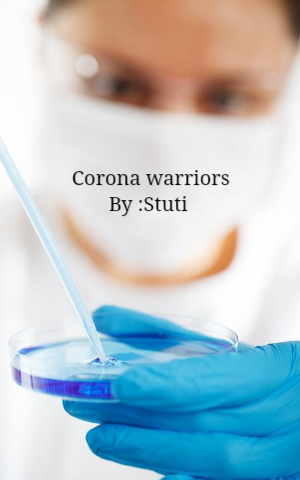

Corona Warriors
Corona Warriors


Few years ago we faced the Pulwama attack,
Warriors attacked from behind a stack.
Our warriors won and defeated them,
This was a story told by our ma'am.
After some years the situation was bad,
Suffering from it people went to bed.
Warriors couldn't fight against them,
As invisibility of enemies caused a problem.
Some people who were our supermen,
With the fright, they never ran.
Everyone locked themselves at home,
But these supermen had to roam.
They fought against the enemy without shield,
They fought alone in this field.
To keep everyone safe they went for their duty,
But others at home paid attention to their beauty.
Cleanliness was noticed everywhere,
These supermen didn't have time to spare.
They didn't tense for their own selves,
As they are our real elves.
They made everyone understand,
To ignore the public gathering ends.
That's what these warriors tried to teach,
From stopping the virus to come and reach.
They walked on the paths when the world was stopped,
They made the places broomed and mopped.
We citizens can safely stay at home,
And help the world defeat these covid zones.
We all should salute our corona warriors,
Which are our supermen.
We, students, want to hear the story from ma'am,
That we defeated our enemies once again.